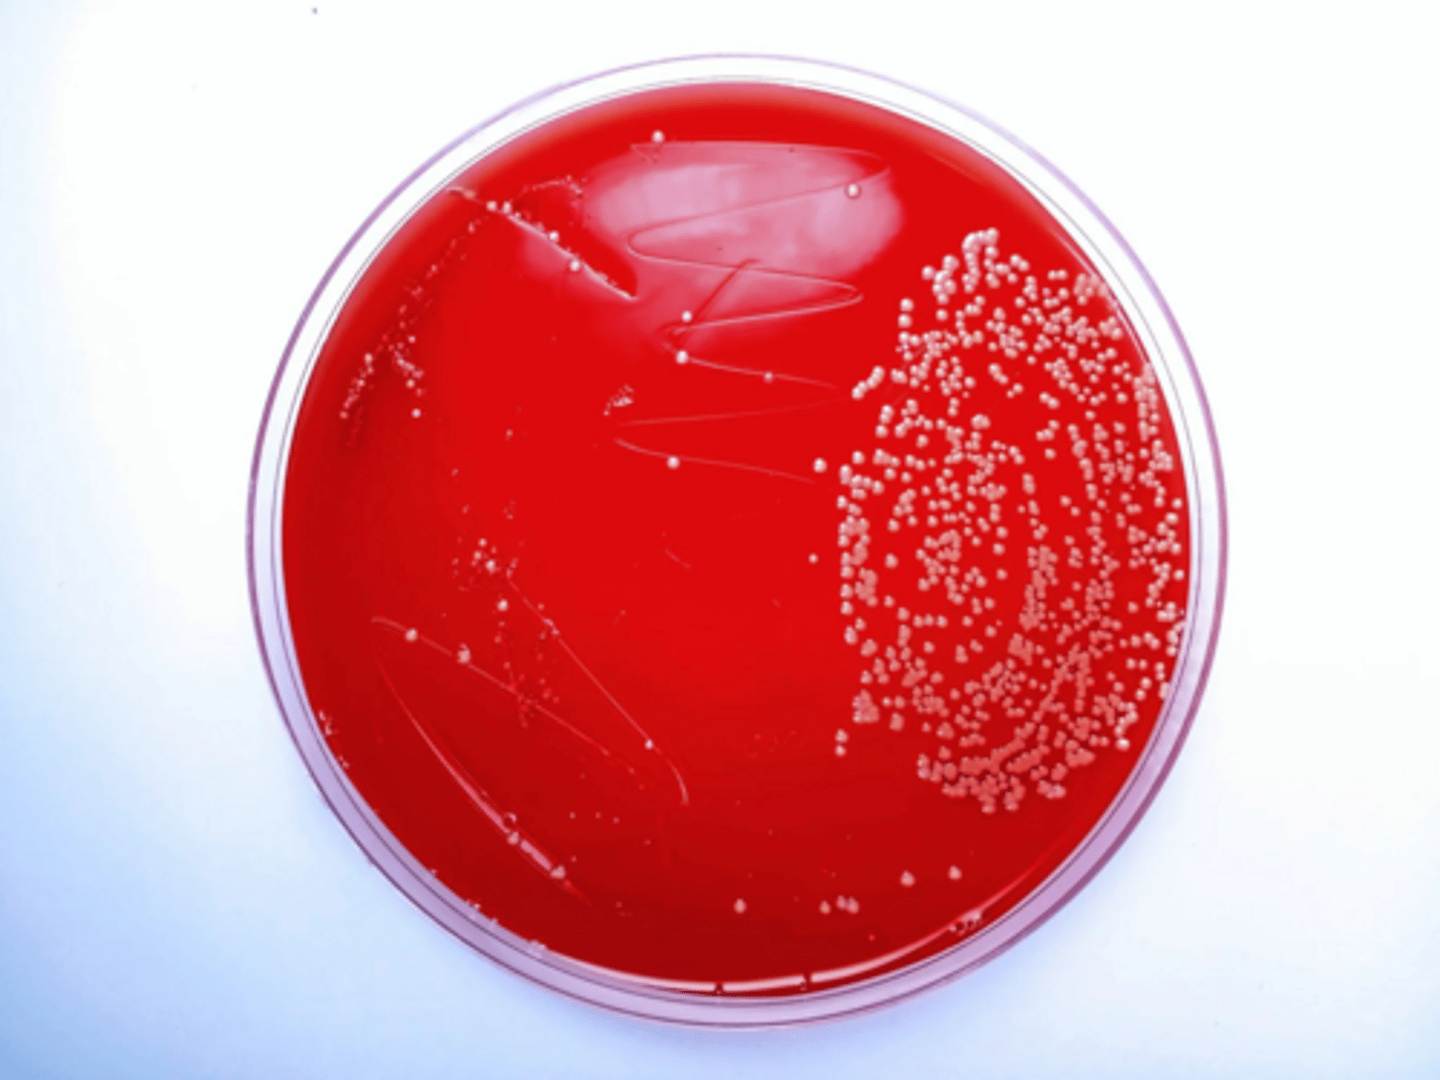
<p>Pink.</p>
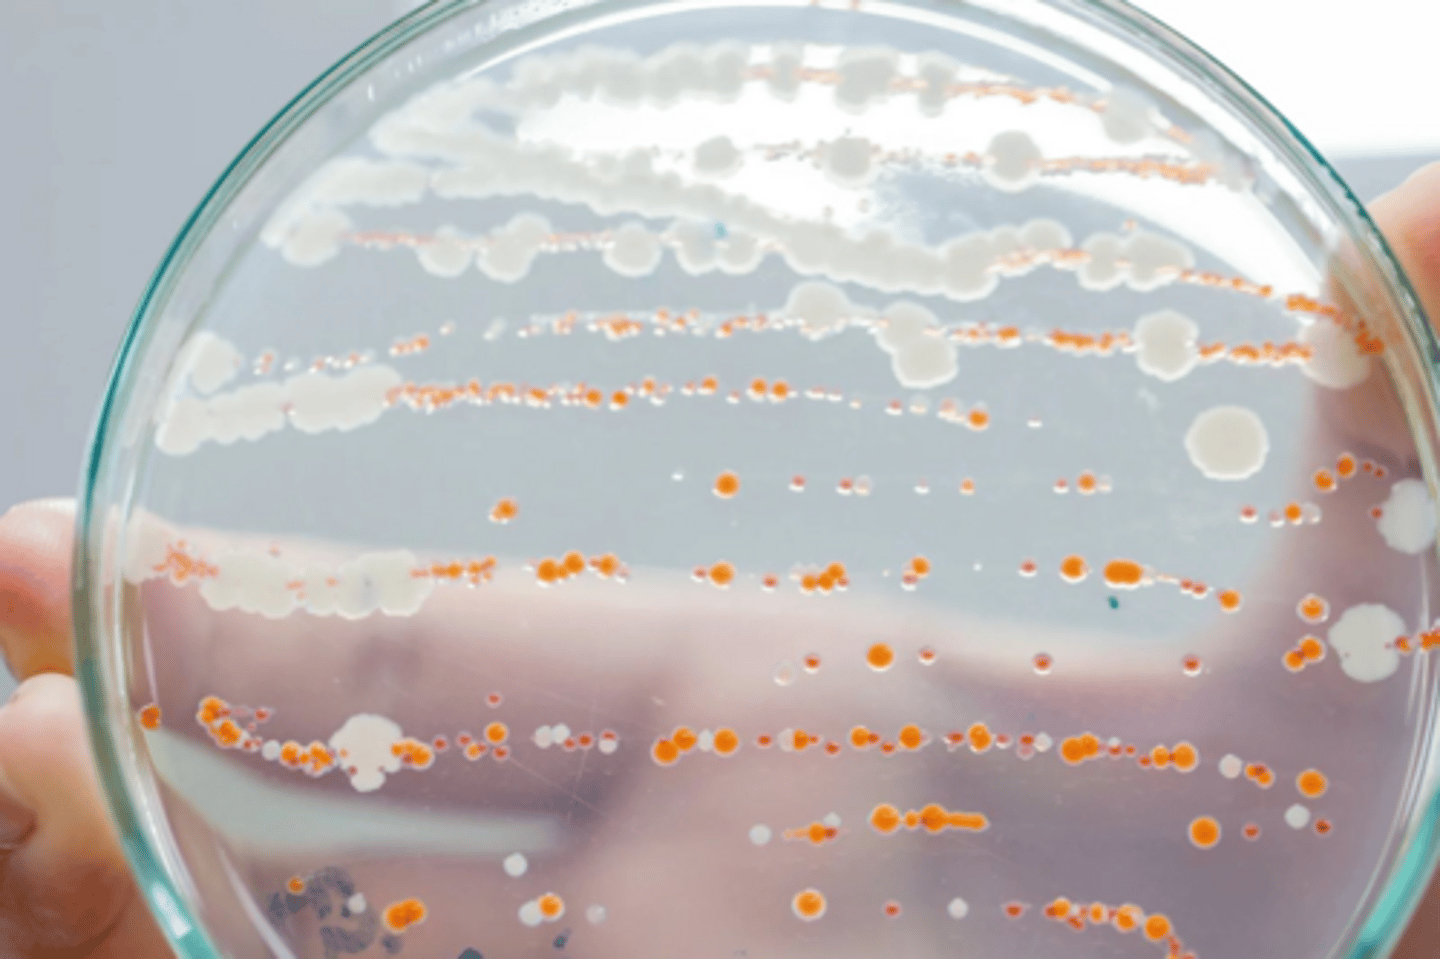
<p>Dark green colonies.</p>

Spring 2026, Feb 17 - Differential, Selective Media, and Key Biochemical Reactions
1/78
There's no tags or description
Looks like no tags are added yet.
Name | Mastery | Learn | Test | Matching | Spaced | Call with Kai |
|---|
No analytics yet
Send a link to your students to track their progress
79 Terms
Mycobacterium tuberculosis stains acid fast due to the
presence of mycolic acid in its cell wall.
This test differentiates Streptococcus pyogenes from other beta-hemolytic streptococci.
The Bacitracin sensitivity test.
What is lipopolysaccharide?
A major component of the outer membrane of Gram-negative bacteria, contributing to their structural integrity and immune response.
What is the Bile solubility test used for?
To differentiate Streptococcus pneumoniae from other alpha-hemolytic streptococci.
Coagulase Test
A test used to identify Staphylococcus aureus by its ability to coagulate plasma.
What does a positive lactose utilization test indicate?
A color change in the media from pinkish red/red to yellow, indicating lactose fermentation.
Which Gram (-) rod appears slimy, white, and somewhat translucent when grown on agar?
Klebsiella pneumoniae.
What is the appearance of non-fermenters on EMB agar?
Clear colorless colonies.
What is the significance of Helicobacter pylori?
It is a gram-negative helical bacterium identified as the cause of gastric ulcers.
What are common causes of fungal meningitis?
Histoplasma, Cryptococcus neoformans, and Candida albicans.
What color do colonies turn on MacConkey agar for lactose fermenters?
Pink.
What does the Urease test detect?
The ability of an organism to hydrolyze urea to ammonia and carbon dioxide.
What is the function of the indole test?
To determine the ability of an organism to produce indole from tryptophan.
What is the significance of the gelatinase test?
To determine the ability of an organism to hydrolyze gelatin.
What are the biochemical characteristics of M. tuberculosis?
Acid fast positive, Niacin negative, Urease negative.
What is the appearance of colonies of Clostridium on culture?
They may have a characteristic grapelike odor when grown in culture.
What does a positive Voges-Proskauer test indicate?
The presence of acetoin in the culture.
What is the role of Potato dextrose agar?
It is used to induce conidia formation in filamentous fungi.
What does the term 'beta hemolysis' refer to?
The complete lysis of red blood cells in the agar surrounding the bacterial colony.
What is the significance of the citrate utilization test?
To determine if an organism can use citrate as its sole carbon source.
What is the appearance of Salmonella on HE agar?
Dark green colonies.
What is the primary use of the starch hydrolysis test?
To determine the ability of an organism to hydrolyze starch.
What does a positive result in the methyl red test indicate?
The organism produces stable acid end products from glucose fermentation.
What is the significance of the pyrazinamidase test?
To identify Mycobacterium tuberculosis based on its ability to hydrolyze pyrazinamide.
What is the appearance of colonies of Pseudomonas on culture?
They may have a characteristic greenish hue due to the production of pyocyanin.

Clue cells
Vaginal epithelial cells that have a stippled appearance due to the presence of bacteria, often associated with bacterial vaginosis.
Metachromatic granules
Granules that store phosphate and can be stained with specific dyes, often found in certain bacteria like Corynebacterium.
Kinyoun stain
A cold method of staining used to identify acid-fast bacteria, similar to the Ziehl-Neelsen stain but does not require heat.
Ziehl-Neelsen stain
A staining technique used to identify acid-fast bacteria, such as Mycobacterium species, using heat to drive the dye into the cells.

Fite-Faraco stain
A special stain used to visualize Mycobacterium leprae in tissue sections.
Warthin-Starry Silver stain
A silver staining technique used to identify spirochetes and certain bacteria in tissue samples.
RBC clumping at cold temps
A phenomenon where red blood cells aggregate at lower temperatures, often seen in certain infections.
High burden of infected macrophages
A condition where macrophages are heavily infected with pathogens, indicating a significant immune response.
Neisseria meningitidis
A pathogenic bacterium responsible for meningococcal disease, known for causing meningitis and septicemia.
Gardnerella vaginalis
A bacterium associated with bacterial vaginosis, characterized by an imbalance of normal vaginal flora.
Treponema pallidum
The bacterium that causes syphilis, a sexually transmitted infection.
Neisseria gonorrhoeae
The bacterium responsible for gonorrhea, a common sexually transmitted infection.
Chlamydia
A genus of bacteria that are obligate intracellular pathogens, often causing sexually transmitted infections.
Muramic acid
A component of bacterial cell walls, absent in Chlamydia, contributing to their weak Gram-negative reaction.
Lipopolysaccharide
A major component of the outer membrane of Gram-negative bacteria, absent in Chlamydia.
Francisella tularensis
The causative agent of tularemia, a highly infectious zoonotic disease.
Brucella spp.
A genus of bacteria that cause brucellosis, often transmitted from animals to humans.
Yersinia pestis
The bacterium responsible for the plague, transmitted through flea bites or contact with infected animals.
Smallpox
A highly contagious and deadly disease caused by the variola virus, eradicated through vaccination.
Mycolic acid
Long-chain fatty acids found in the cell walls of mycobacteria, contributing to their virulence.
Mannitol Salt Agar
A selective medium for isolating Staphylococcus species, containing high salt concentrations.
Oxidase test
A biochemical test used to identify bacteria that produce cytochrome c oxidase, part of the electron transport chain.
Sabouraud dextrose agar (SDA)
A culture medium used for the isolation of fungi, particularly dermatophytes and yeasts.
Blood Agar
A rich medium used to culture a wide variety of bacteria, allowing for the observation of hemolytic activity.
Modified Dixon Agar
A selective medium used for the isolation of Malassezia species, a type of yeast.
Buffered charcoal yeast extract agar
A culture medium used to isolate Legionella species from clinical specimens.
Eosin methylene blue agar
A selective and differential medium for gram-negative bacteria, particularly enteric bacteria.
What is Blood Agar?
A type of growth medium that supports the growth of a wide variety of bacteria, enriched with red blood cells to facilitate the detection of hemolytic activity.
What is Milk Agar?
A growth medium used to culture bacteria, particularly those that can hydrolyze casein, a protein found in milk.
What is Casein Hydrolysis Agar?
A selective medium used to test for the ability of bacteria to hydrolyze casein into amino acids.
What is MacConkey Agar?
A selective and differential culture medium for bacteria that inhibits the growth of Gram-positive organisms and differentiates Gram-negative bacteria based on lactose fermentation.

What does a positive coagulase test indicate?
It indicates the presence of Staphylococcus aureus, which is coagulase-positive, differentiating it from other staphylococci.
What is the significance of Mycobacteria grown in MGIT 960 broth?
They demonstrate fluorescence when exposed to UV light, indicating the presence of mycobacterial species.
Which species are coagulase-negative staphylococci?
Staphylococcus epidermidis and Staphylococcus intermedius are examples of coagulase-negative staphylococci.
What is Cording in microbiology?
The aggregation of acid-fast bacilli into a suprastructure, often seen in Mycobacterium species.
What is the optimal temperature range for Vibrio spp. growth?
Vibrio spp. can grow over a wide range of temperatures, but their growth rate is accelerated at lower temperatures.
What is Brain Heart Infusion used for?
It is a non-selective media commonly used for the cultivation of fastidious organisms.
What are Lancefield groups?
Different serotypes of Streptococcus based on cell wall carbohydrates.
What is Streptococcus bovis?
A non-enterococcal group D streptococcus that can be differentiated from enterococci.
What is Lactococcus thermophilus?
A species of bacteria known for its rapid growth at high temperatures and active fermentation of milk.
What medium is used for culturing Mycobacterium species?
Lowenstein-Jensen medium is commonly used for culturing Mycobacterium species.
What is the purpose of the catalase test?
To differentiate between catalase-positive bacteria, such as Staphylococcus, and catalase-negative bacteria, such as Streptococcus.
What sugars are used in TSI agar?
Maltose, glucose, and sucrose are the sugars used in Triple Sugar Iron (TSI) agar.
What is the significance of the Giemsa stain?
It is used to visualize Chlamydia trachomatis inclusion bodies and other cellular structures.
What type of medium is Eaton's Agar?
A specialized medium used for the culture of Mycoplasma pneumoniae.
What does a positive oxidase test indicate?
It indicates the presence of certain bacteria, such as Pseudomonas, which are oxidase-positive.
What is the role of nitrogen gas in microbiology?
Nitrogen gas can enhance the growth of capnophilic organisms, which require increased carbon dioxide levels.
What is the significance of the BACTEC 12B medium?
It is used for the culture and detection of mycobacterial species.
What is the function of the Wright's stain?
It is used to identify metachromatic granules in Corynebacterium diphtheriae.
What is the function of the Castaneda Stain?
It is used to identify Mycobacterium species in clinical samples.
What is the characteristic of E. coli O157 on MAC plate?
It shows a characteristic colony morphology that can be identified on MacConkey agar.
What does the coagulase test differentiate?
It differentiates highly pathogenic Staphylococcus aureus from other less pathogenic staphylococcal species.
What is the significance of Hektoen enteric agar?
It is used to isolate and differentiate enteric Gram-negative pathogens, particularly Salmonella and Shigella.
What is the role of the oxidase test?
To identify bacteria that produce cytochrome c oxidase, a key enzyme in the electron transport chain.